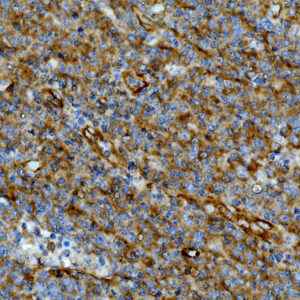
Anti-ALK/CD246, Clone ALK/1031
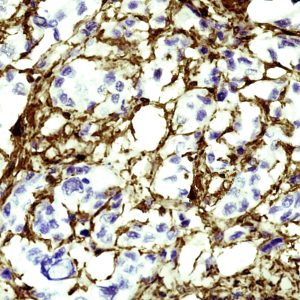
AMA48

A
Showing 21–35 of 35 resultsSorted by latest
-
Anti-ALK/CD246, Clone ALK/1031
Price range: $269.00 through $1,125.00 Select options This product has multiple variants. The options may be chosen on the product page -

Anti-ATRX, Clone D-5
Price range: $269.00 through $1,139.00 Select options This product has multiple variants. The options may be chosen on the product page -

Anti-Anti-IL-1a, Clone IL1A/3981
Price range: $269.00 through $1,135.00 Select options This product has multiple variants. The options may be chosen on the product page -

Anti-Adipophilin
Price range: $269.00 through $1,305.00 Select options This product has multiple variants. The options may be chosen on the product page -
Anti-Actin, Muscle Specific, Clone SPM160
Price range: $269.00 through $1,349.00 Select options This product has multiple variants. The options may be chosen on the product page -

Anti-Annexin A1
Price range: $269.00 through $1,375.00 Select options This product has multiple variants. The options may be chosen on the product page -

Anti-ACTH, Clone-AH26
Price range: $345.00 through $995.00 Select options This product has multiple variants. The options may be chosen on the product page -

Anti-Alpha-1-Antichymotrypsin
Price range: $250.00 through $935.00 Select options This product has multiple variants. The options may be chosen on the product page -

Anti-Actin; Smooth Muscle
Price range: $260.00 through $1,465.00 Select options This product has multiple variants. The options may be chosen on the product page -

Anti-Alpha-Tubulin
Price range: $300.00 through $905.00 Select options This product has multiple variants. The options may be chosen on the product page -

Anti-Alpha-Actinin
Price range: $335.00 through $965.00 Select options This product has multiple variants. The options may be chosen on the product page -

Anti-Actin; Muscle-Specific
Price range: $416.00 through $1,195.00 Select options This product has multiple variants. The options may be chosen on the product page -

Anti-Adenovirus
Read more -

Anti-Adenovirus
Price range: $269.00 through $1,125.00 Select options This product has multiple variants. The options may be chosen on the product page -

Anti-Alpha-Fetoprotein (AFP)
Price range: $269.00 through $1,295.00 Select options This product has multiple variants. The options may be chosen on the product page

